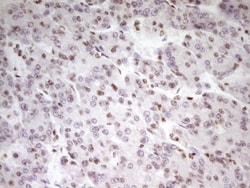
SP110 Antibody (OTI4C1), Novus Biologicals 0.1mL; Unlabeled:Antibodies,

missing translation for 'onlineSavingsMsg'
Learn More
Learn More
SP110 Antibody (OTI4C1), Novus Biologicals™
Mouse Monoclonal Antibody
Brand: Novus Biologicals NBP2-45919
This item is not returnable.
View return policy
Description
Ensure accurate, reproducible results in Western Blot, Immunohistochemistry
SP110 Monoclonal specifically detects SP110 in Human samples. It is validated for Western Blot, Immunohistochemistry.
Specifications
| SP110 | |
| Monoclonal | |
| 1 mg/mL | |
| Western Blot 1:2000, Immunohistochemistry 1:150 | |
| FLJ22835, IFI41, IFI75, interferon-induced protein 41, 30kD, Interferon-induced protein 41/75, interferon-induced protein 75, 52kD, IPR1, phosphoprotein 41, phosphoprotein 75, SP110 nuclear body protein, Speckled 110 kDa, Transcriptional coactivator Sp110, VODI | |
| Mouse | |
| 61.7 kDa | |
| 0.1 mL | |
| Primary | |
| Human | |
| Purified |
| Western Blot, Immunohistochemistry | |
| OTI4C1 | |
| Unconjugated | |
| PBS (pH 7.3), 1.0% BSA and 50% Glycerol with 0.02% Sodium Azide | |
| SP110 | |
| Human recombinant protein fragment corresponding to amino acids 232-521 of human SP110(NP_004501) produced in E.coli. | |
| Immunogen affinity purified | |
| RUO | |
| 3431 | |
| Store at -20C. Avoid freeze-thaw cycles. | |
| IgG1 |
Product Content Correction
Your input is important to us. Please complete this form to provide feedback related to the content on this product.
Product Title
For Research Use Only
Spot an opportunity for improvement?Share a Content Correction